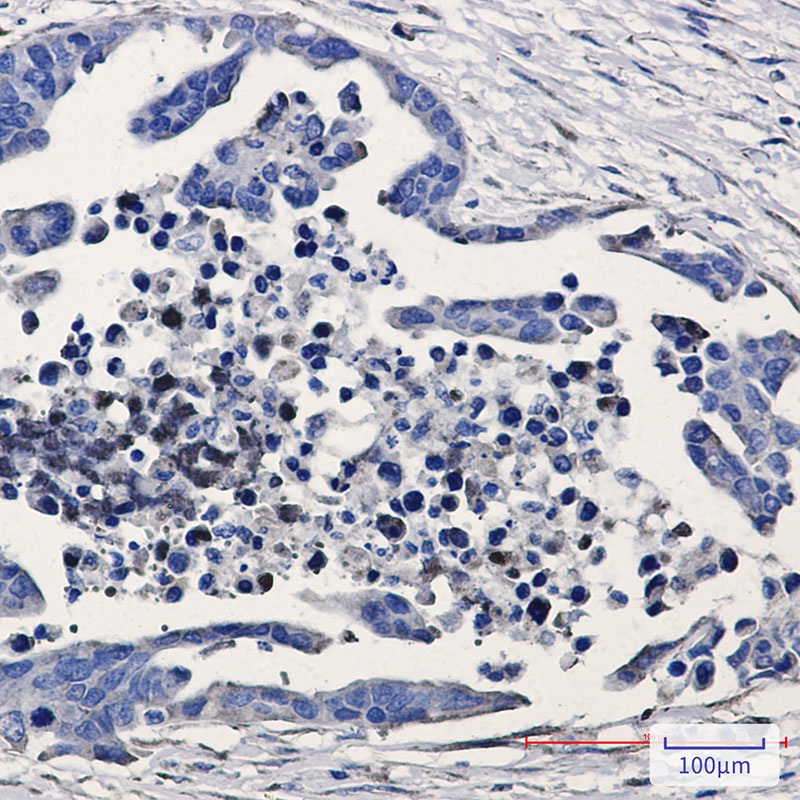
产品细节图片2

相关产品推荐更多 >
万千商家帮你免费找货
0 人在求购买到急需产品
- 详细信息
- 文献和实验
- 技术资料
- 抗体名:
GSK3 beta Rabbit mAb抗体
- 抗体英文名:
GSK3 beta Rabbit mAb
- 靶点:
GSK3B
- 浓度:
0.3 mg/ml
- 应用范围:
IHC-P, WB
- 适应物种:
Hamster, Human, Rat
- 保质期:
6-12个月
- 抗原来源:
详询
- 目录编号:
orb1563090
- 级别:
科研级
- 库存:
88
- 供应商:
biorbyt
- 标记物:
Unconjugated
- 克隆性:
Monoclonal
- 保存条件:
参考说明书
- 形态:
Liquid
- 亚型:
IgG
- 免疫原:
A synthetic peptide of human GSK3 beta
- 规格:
20 ul
别名:GSK3B; Glycogen synthase kinase-3 beta; GSK-3 beta; Serine/threonine-protein kinase GSK3B
免疫原:A synthetic peptide of human GSK3 beta
克隆性:R09-7G8
分子量:Calculated MW: 47 kDa; Observed MW: 47 kDa
应用稀释比例:WB: 1/500-1/1000 IHC: 1/50-1/100
防腐剂:50mM Tris-Glycine(pH 7.4), 0.15M NaCl, 40%Glycerol, 0.01% sodium azide and 0.05% rAlbumin.
纯化:Affinity Purified
保存说明:Maintain refrigerated at 2-8°C for up to 2 weeks. For long term storage store at -20°C in small aliquots to prevent freeze-thaw cycles.
UniProt ID:P49841
Note:For research use only.

风险提示:丁香通仅作为第三方平台,为商家信息发布提供平台空间。用户咨询产品时请注意保护个人信息及财产安全,合理判断,谨慎选购商品,商家和用户对交易行为负责。对于医疗器械类产品,请先查证核实企业经营资质和医疗器械产品注册证情况。
 文献和实验
文献和实验真爱满行囊 我最近在体外细胞做的关于gsk3-beta功能问题,发现药物处理以后,gsk-3-beta的总表达量下调,如果是这样的话 1、我是否能够得出gsk-3-beta的活性下调的结论? 2、是否还有必要做非活性形式的表达量?我的理解是,基础状态下,gsk-3beta维持的是低活性状态,如果总量都下调了,那应该能够得出活性降低的结论了吧? 3、另外,在这种情况下我是否有必要去做gsk-3-beta的216位点的活性形式的表达
【求助】rabbit beta-globin intron这个内含子有什么作用啊?
maiqitu 在构建载体的时候要往里面加rabbit beta-globin intron,请问是为什么呢?谢了啊 zhujoker 那你到底是构建什么载体啊?还需要往里面加rabbit beta-globin intron,我也觉得奇怪。但是有一个东西是可能的,那就是你构建的是miRNA表达质粒,因为miRNA位于大多数基因间,也就是位于内含子得地方?不知道是不是你所想要的,呵呵! hcai55
v468. chapter 4 WNT 细胞通路 检测细胞GSK3活性与表达水平
., and Cohen, P. (1980) Glycogen synthase kinase-3 from rabbit skeletal muscle. Separation from cyclic-AMP-dependent protein kinase and phosphorylase kinase. Eur. J. Biochem. 107, 519–527. 6. Cohen, P. and Goedert, M. (2004) GSK3 inhibitors: development
 技术资料
技术资料暂无技术资料 索取技术资料











